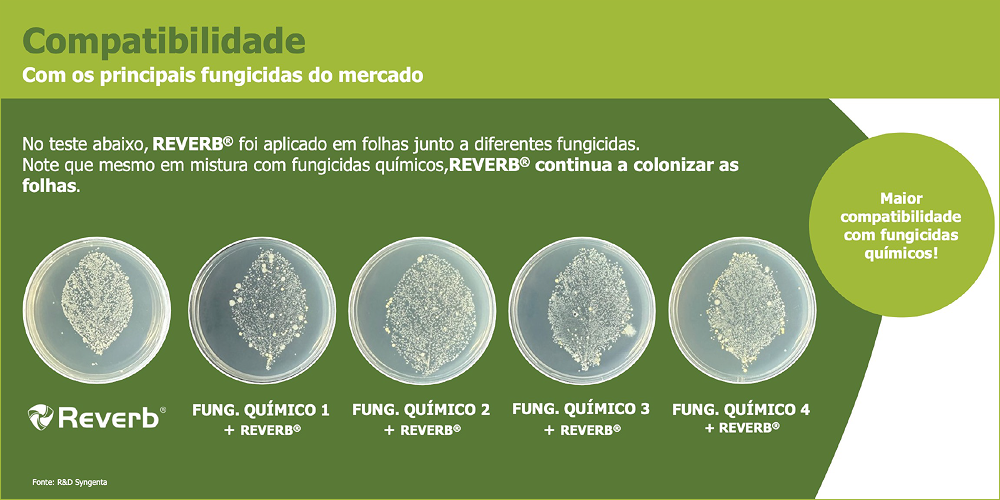
miolo-REVERB-img02
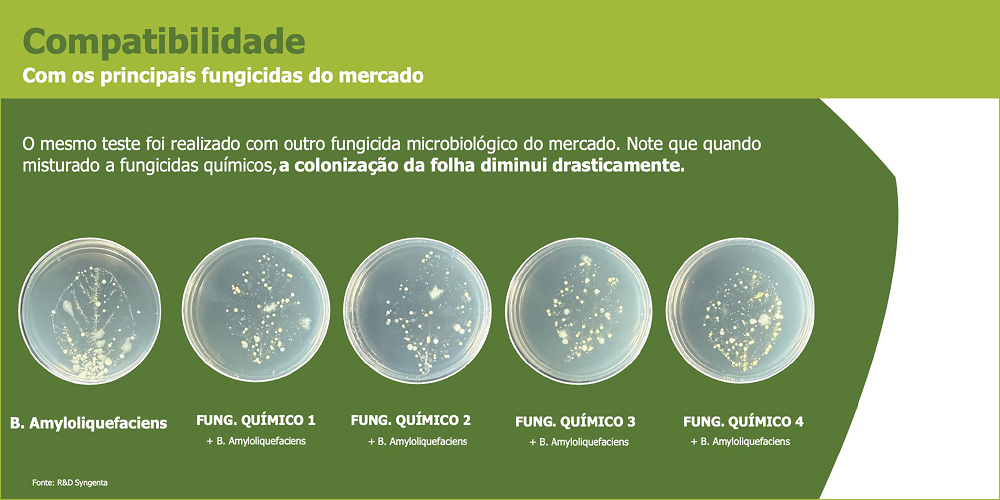
miolo-REVERB-img02B

O Brasil será o país com maior crescimento de uso de biológicos no mundo
Por GTEC Boletins Segunda-feira, 1 de dezembro de 2025
No cenário atual, de uma agricultura moderna e globalizada, os agricultores precisam contar com soluções de insumos agrícolas cada vez mais sustentáveis, que possibilitem o aumento da produtividade das lavouras, sem prejudicar os recursos naturais disponíveis e atendendo às crescentes exigências dos consumidores em relação à produção de alimentos que consomem.
Por isso, a Syngenta Biologicals tem um portfólio completo de produtos biológicos para a agricultura, que traz o potencial ilimitado da inovação movida pela natureza com base científica ao oferecer as melhores ferramentas com soluções para acelerar ainda mais o avanço de um agronegócio cada dia mais sustentável e produtivo.
A Syngenta Biologicals apresenta 2 grandes lançamentos: o inseticida microbiológico NETURE™ para o controle das principais pragas do milho, soja e outras culturas e o fungicida microbiológico REVERB® no combate das doenças da soja e outras culturas.
Saiba mais sobre eles.

NETURE™ abre novos horizontes no controle de pragas; se destacando principalmente por sua alta eficiência no controle da cigarrinha do milho, sendo também eficiente em percevejos, mosca branca e outros sugadores. Tudo isso aliando praticidade ao agricultor, não necessitando de armazenamento refrigerado e sendo compatível com os principais defensivos químicos.
Tendo em sua formulação dois microorganismos, a Pseudomonas Chlororaphis e a Pseudomonas Fluorescens, que são 2 cepas exclusivas e agem de maneira complementar, promovendo:
- Alta eficácia
- Residual
- Controle de Espectro
Confira a eficiência de NETURE™ nas pragas de difícil controle, e a comparação dos demais benefícios de NETURE™ em comparação a outros Inseticidas Biológicos:


MODOS DE AÇÃO
NETURE™ tem diferentes modos de ação: rápido poder de ação por conter metabólitos prontamente disponíveis, produção de proteína que ao serem ingeridas pelos insetos, tem forte ação sobre os sistemas nervoso e digestivo, e produção de terpenos que causam a alta repelência dos insetos.


POSICIONAMENTOS



REVERB® é um fungicida microbiológico inovador; é o parceiro biológico que potencializa a ação dos fungicidas químicos no controle e manejo de resistência das manchas na soja, atuando também nos patógenos da palhada. Ainda, promove o crescimento vigoroso das plantas, aumentando a produtividade.

Eficiência
- Potencializa o efeito dos fungicidas em Mancha Alvo, Antracnose, Septoria, Cercospora, Mofo Branco e mais 24 alvos.
- Ação em “anomalia da soja” Quebramento de hastes e podridão de grãos.
- Manejo de resistência : múltiplos modos de ação no controle de manchas.
- Efeito Bioativador: promove crescimento e vigor.
Conveniência
- Armazenamento: 2 Anos de validade sem refrigeração
- Compatível com os principais Fungicidas e Inseticidas
A formulação de REVERB® é inovadora e exclusiva garantindo que as bactérias estejam 100% no formato de endósporos viáveis. Os endósporos são resistentes a temperatura, raios UV, e interação com os produtos químicos que estarão na mistura de tanque.
É isso que faz REVERB® oferecer total conveniência ao agricultor em comparação aos demais fungicidas microbiológicos: maior tempo de prateleira, não necessitar de refrigeração e ter grande compatibilidade com químicos.

Múltiplos modos de ação com eficiência no manejo de resistência das manchas.
São 4 etapas de ação, controlando os patógenos de forma DIRETA e INDIRETA:
- CONTROLE IMEDIATO: produção de metabólitos de ação fungicida;
Diferente dos demais fungicidas microbiológicos, REVERB® apresenta metabólitos prontamente disponíveis que conferem atividade fungicida em sua composição, ou seja, iniciam sua ação imediatamente após a aplicação do produto.
É por isso que REVERB® tem a ação mais rápida entre todos os fungicidas microbiológicos! - COMPETIÇÃO COM O PATÓGENO: rápida colonização das folhas Além de continuarem a produção de metabólitos, as bactérias presentes em REVERB® começam a se reproduzir rapidamente, colonizando a folha “competindo” por espaço com os patógenos.

- EFEITO PREVENTIVO: formação de biofilme protetor; Depois de colonizarem as folhas, as bactérias de REVERB® iniciam a produção de exsudados formando um biofilme para se protegerem de luz solar e outros patógenos. Ao formarem esse “escudo” também protegem a folhas da chegada de novos esporos de patógenos.
- VIGOR E DESENVOLVIMENTO DAS PLANTAS: resistência sistêmica induzida. As bactérias presentes em REVERB® produzem e fornecem para as plantas fito hormônios e substâncias indutoras de resistência (ex. auxina); proporcionando maior crescimento e vigor para as plantas, além de maior tolerância ao ataque de patógenos.
POSiCIONAMENTO NA SOJA
O melhor momento do controle de manchas, antracnose e “anomalia” ocorre nas primeiras aplicações.

NETURE® e REVERB® não necessitam de refrigeração e são compatíveis com os principais defensivos químicos, oferecendo praticidade aos agricultores.
Com NETURE® e REVERB®, a Syngenta Biologicals reforça seu compromisso com soluções eficientes para os agricultores, tornando o manejo de pragas e doenças mais simples e eficaz.

